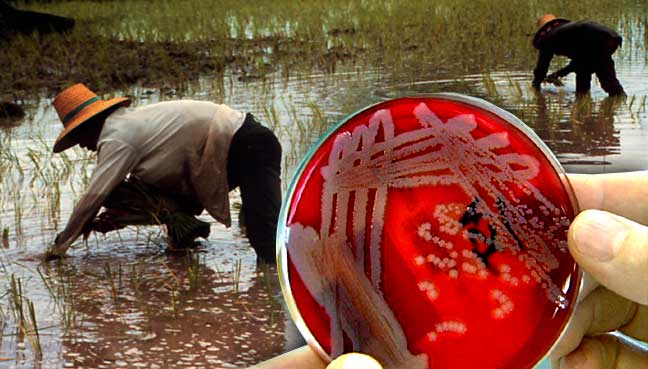

Bệnh Melioidosis hay do trực khuẩn gram âm Burkholderia pseudomallei có tên “Melioidosis” hay bệnh Withmore, loại vi khuẩn này tồn tại trong môi trường tự nhiên gây ra bệnh khi có điều kiện. Đặc điểm lâm sàng kinh điển là gây viêm phổi và áp xe đa ổ có thể liên đới đến nhiều cơ quan khác nhau, bệnh có tỷ lệ tử vong cao, có thể lên đến 40%. Trực khuẩn này là nguyên nhân gây nhiễm khuẩn toàn thân quan trọng ở các cộng đồng cư dân ở các quốc gia thuộc Đông Nam Á và phía Bắc Úc. Sự phân bố toàn cầu của tác nhân gây bệnh này đang lan rộng một phần nhờ những cải thiện về chẩn đoán vi sinh học, mặt khác là do số người đi du lịch và sự trở về của các nhân viên quân sự đến các vùng bệnh lưu hành ngày càng tăng.
Phân loại khoa học, bệnh thuộc nhóm bệnh nhiễm trùng (infectious diseases), phân loại bệnh tật quốc tế ICD-10 là A24.1-A24.4, theo ICD-9-CM là 025, theo mã bệnh DiseasesDB là 30833, theo phân loại eMedicine là emerg/884 và theo MeSH là D008554. Điều này giúp cho các nhà chuyên môn dễ dàng tra cứu thông tin về căn bệnh nguy hiểm này. Trước đây, bệnh này có nhiều tên gọi khác nhau như bệnh giả tuyến “Pseudoglanders”, bệnh Whitmore (sau khi Captain Alfred Whitmore mô tả bệnh lần đầu tiên), bệnh Nightcliff gardener (Nightcliff là vùng ngoại ô của Darwin, Australia nơi có bệnh Melioidosis lưu hành),bệnh liên quan ruộng lúa “Paddy-field disease”và bệnh Morphia injector's septicaemia.
Đặc điểm vi khuẩn B. pseudomallei
B. pseudomallei thuộc giống Burkholderia, gồm có trên 40 loài. Các thành viên gây bệnh khác gồm B. mallei - tác nhân gây bệnh sưng hạch ở ngựa và các loài thú có móng khác (ngựa, lừa) và có độc tính cao đối với con người và loài B. cenocepacia - một tác nhân gây nhiễm khuẩn cơ hội quan trọng ở các bệnh nhân mắc chứng xơ hóa nang.

Hình 1
Giống này cũng gồm B. thailandensis - một tác nhân cùng đồng thời có mặt với loài B. pseudomallei trong đất ở Thái lan, Úc và loài B. oklahomensis được tìm thấy ở miền Trung và Tây của Mỹ. Hai loài hiếm này, chắc rằng gây bệnh và ít độc lực hơn nhiều (bằng một yếu tố > 100.000) so với B. pseudomallei ở chuột hamsters và chuột nhắt.
Bộ gene của vi khuẩn B. pseudomallei gồm hai cặp nhiễm sắc thể có 4,07 và 3,17 megabase, đến nay nó là một trong số bộ gen di truyền của vi khuẩn phức tạp nhất đã được giải mã. Loài B. pseudomallei có chung một tập hợp gồm 2.590 gen với các thành viên khác của giống Burkholderia và có tính động học cao. Có khoảng 86% bộ mã gen di truyền vi khuẩn B. pseudomallei K96243 dạng tiền type hay gặp nhất trong tất cả dòng và đại diện bộ mã gen di truyền vùng tâm, có 14% thay đổi hiện diện trong tất cả các chủng phân lập. Miền có thể biến thiên gồm nhiều đảo của bộ gen di truyền chứa DNA lấy được từ các vi khuẩn khác.
Các cụm gen của bộ mã di truyền liên quan đến tính chất gây độc thích hợp có một tiềm năng nhiễm khuẩn, mặc dầu những kết hợp cụ thể với các kết cục lâm sàng chưa được hiểu rõ. Việc định type gen của nhiều khuẩn lạc B. pseudomallei từ một số vị trí mô ở 4 bệnh nhân mắc bệnh Melioidosis cấp tính đã cho thấy tính đa dạng di truyền đáng kể ở một bệnh nhân duy nhất, biểu thị năng lực của vi khuẩn để tiến hóa nhanh bên trong cơ thể vật chủ.

Hình 2
Phân tích chuyên sâu cho thấy nhiều yếu tố gây độc tiềm năng của loài B. pseudomallei đã từng được mô tả, nhưng tính chất quan trọng tương đối của mỗi yếu tố gây bệnh cho người vẫn chưa được biết đầy đủ. Hệ thống quorum - sensing ảnh hưởng đến yếu tố hành vi của toàn bộ quần thể vi khuẩn qua chất tiết ngoại bào của N-acyl homoserine lactones. Vi khuẩn B. pseudomallei chứa 3 nhóm gen của hệ thống tiết type III (TTSS) mã hóa các đường hầm bắc cầu với màng tế bào để chuyển giao các phân tử hiệu lực của vi khuẩn vào bào tương tế bào vật chủ. Hệ thống TTSS3, hệ thống kiểu Inv/Mxi-Spa, đóng vai trò quyết định ở nội bào của trực khuẩn bằng thông qua ảnh hưởng đến các tiến trình của vật chủ. Các đột biến TTSS3 gây bất thường sự sống sót nội bào của B. pseudomallei và ngăn cản sự lẫn tránh của vi khuẩn khỏi các hốc nội bào.
Bộ mã di truyền của B. pseudomallei mã hóa 6 hệ thống tiết kiểu VI, có liên quan tới độc tính của vi khuẩn, sự sống sót nội bào và sự cạnh tranh với các nhóm vi khuẩn. Polysaccharide bao, lipopolysaccharide và hai O-polysaccharides bề mặt khác (O-PS; types III O-PS và IV O-PS) là những yếu tố độc tính được phát hiện thêm. Roi có thể có tính chất quan trọng đối với sự di chuyển và xâm nhập tế bào vật chủ của B. pseudomallei, mặc dầu sự quan trọng của nó như là một yếu tố độc tính trong bệnh sinh ở người đang được bàn cãi. Yếu tố 1 gây tử vong của Burkholderia tương tự với yếu tố 1 gây hoại tử độc tế bào của Escherichia coli và giao thoa với sự khởi đầu dịch mã, làm cho sự biến đổi actin của sườn tế bào và cuối cùng gây chết tế bào.
Vi khuẩn Burkholderia pseudomallei còn có tên gọi khác là Pseudomonas pseudomallei, đây làvi khuẩn gram âm, lưỡng cực, hiếu khí, hình roi, di động. Nó nhiễm lên con người và cả động vật và là nguyên nhân gây bệnh Melioidosis. Nó cũng có thể ảnh hưởng hoặc gây bệnh đến các loại thực vật.

Hình 3
B. pseudomallei có chiều dài khoảng từ 2-5 μm và đường kínhtừ 0.4-0.8 μm và cũng có thể sử dụng roi để di chuyển theo hướng tới. Vi khuẩn có thể tăng trưởng bằng chất dinh dưỡng trong một số môi trường nhân tạo, đặc biệt là môi trường chứa nhóm đường betaine và acid amine arginine. Trong nuôi cấy in vitro, nhiệt độ tối ưu cho sự tăng trưởng nhanh của vi khuẩn là khoảng 40°C trong điều kiện pH môi trường trung tính hoặc acid yếu khoảng (pH = 6.8-7.0). Đa số các chủng này có khả năng lên men với đường không sinh hơi (quan trọng nhất là đường glucose và galactose, việc nuôi cấy trước đây thì cũng chuyển hóa thành đường maltose và tinh bột). Vi khuẩn này sản sinh ra cả nội độc tố và ngoại độc tố. Vai trò của các độc tố này được xác định trong quá trình hình thành triệu chứng của bệnh Melioidosis nhưng vẫn chưa được làm sáng tỏ.
Dịch tễ học và Yếu tố nguy cơ
Melioidosis là bệnh chủ yếu theo mùa, 75-81% trường hợp xảy ra suốt mùa mưa. Tỷ lệ mắc mới cao nhất ở giữa 40-60 tuổi, nhưng cũng gặp Melioidosis ở trẻ em. Melioidosis lây nhiễm đến trẻ em qua sữa mẹ từ những người mẹ bị viêm vú do tác nhân gây bệnh này. Vì có đến 80% bệnh nhân mắc Melioidosis có một hoặc nhiều yếu tố nguy cơ đối với bệnh này, mà người ta gợi ý rằng Melioidosis được xem như một nhiễm khuẩn cơ hội mà kết cục không gây tử vong ở người trước đó khỏe mạnh, miễn là bệnh được chẩn đoán sớm và điều trị bằng kháng sinh thích hợp và có sẵn các nguồn lực chăm sóc, điều trị tích cực.

Hình 4
Các yếu tố nguy cơ đối với bệnh Melioidosis gồm đái tháo đường (ở 23-60% bệnh nhân), nghiện rượu (ở 12-39%), bệnh phổi mãn tính (ở 12-27%), bệnh thận mãn tính (ở 10-27%), thalassemia (ở 7%), điều trị với glucocorticoid (< 5%) và ung thư (<5%).
Trong số các khu vực chính ở đó Melioidosis đang lưu hành, nơi tận cùng của lãnh địa phía Bắc Úc và đông bắc Thái Lan đại diện các điểm nóng về bệnh này, với tỷ lệ mới mắc hàng năm lên tới 50/100.000 dân. Melioidosis là nguyên nhân gây tử vong hay gặp hàng thứ 3 của bệnh nhiễm trùng ở đông bắc Thái Lan, chỉ đứng sau nhiễm HIV/AIDS và Lao. Malaysia, Singapore, Việt Nam, Campuchia và Lào cũng là vùng bệnh lưu hành.
Các báo cáo đã mở rộng vùng dịch lưu hành tới các vùng của bán lục địa Ấn Độ, nam Trung Quốc, Hồng Kông, Đài Loan, các đảo khác nhau ở Thái Bình Dương và Ấn Độ Dương, những phần của châu Mỹ. Các trường hợp bệnh lẻ tẻ đã được báo cáo ở Nigeria, Gambia, Kenya, và Uganda, nhưng phạm vi bệnh ở châu Phi vẫn còn chưa được xác định chắc chắn.
Phạm vi bệnh Melioidosis ở châu Mỹ đang còn được làm rõ. Hai trường hợp đã được báo cáo ở Mỹ mà người ta cho rằng bệnh nhân đã từng bị nhiễm ở Honduras.
Melioidosis nặng ở Puerto Rico đã từng được mô tả ở một bệnh nhân mắc bệnh u hạt mãn tính và ở một bệnh nhân mắc bệnh đái tháo đường, cả hai bệnh nhân trên bị mắc bệnh vào mùa mưa.
Các trường hợp Melioidosis lẻ tẻ đã từng được báo cáo ở Ecuador, Guadeloupe và Aruba và sự xuất hiện Melioidosis ở Brazil là một ví dụ về việc phát hiện bệnh tăng lên trong các khu vực ở đó bệnh đã được quan tâm chú ý và việc sử dụng các test chẩn đoán. Aruba đã là khu vực của một vụ dịch ở cừu, dê và lợn trong những năm của thập kỷ 1950 và có thể đã là nơi đối với một bệnh nhiễm mắc phải ở một đứa trẻ đã bị xơ hóa nang mà được trình bày mới đây mắc Melioidosis ở Massachusetts.
Những ổ sinh thái đặc biệt này của B. pseudomallei dường như thay đổi trong số những nơi ở đó bệnh Melioidosis đang lưu hành, nhưng dữ liệu mới đây mà B. pseudomallei đang quần cư và đang bùng phát ở những phần gốc rễ và phần không gian của các bải cỏ bản địa và được nhập khẩu ở bắc Úc cung cấp nhận thức về dịch tễ học và tiềm năng phân tán toàn cầu của bệnh.

Hình 5
Đề kháng từ vật chủ với vi khuẩn B. pseudomallei
B. pseudomallei có thể xâm nhập, sống, và nhân lên ở cả tế bào thực bào lẫn tế bào không thực bào, và hoạt động nội bào của nó được xem là quan trọng đối với tính chất sinh bệnh. Sau khi vào nội bào, vi khuẩn này có thể lẫn tránh hốc thực bào và nhân lên bên trong Cytosol của tế bào vật chủ. Rồi vi khuẩn B. pseudomallei có thể gây cảm ứng các đuôi actin được tổng hợp từ những sợi actin mà trở nên bị phân cực và cho phép chuyển động bên trong tế bào, với sự hình thành kế tiếp của các nhú ra màng tế bào và trực chỉ lan tỏa vi khuẩn từ tế bào này đến tế bào khác.

Hình 6
B. pseudomallei có thể xâm nhập đại thực bào và rồi có thể sống sót và nhân lên trong suốt những thời kỳ dài. Mặc dầu một số vi khuẩn bị phá hủy sau khi bị thực bào, một số khác thoát khỏi các hốc tiêu khuẩn nội bào hoặc trực tiếp bị phá vỡ ở khoang ngoại bào hoặc nhiễm vào các tế bào khác thông qua sự nhú màng trên cơ sở cấu tạo actin. Các thụ thể Toll-like (TLRs) được biểu thị ở các tế bào vật chủ là phát hiện trước tiên cho sự xâm nhập của B. pseudomallei, làm cho yếu tố nhân κB (NF-κB) gây cảm ứng sự hoạt động của đáp ứng miễn dịch thông qua việc giải phóng các cytokine tiền viêm.
Đáp ứng TLR được điều hòa một cách chặt chẽ: khởi động thụ thể được biểu thị trên các tế bào 1 dòng tủy (triggering receptor expressed on myeloid cells 1_TREM-1) khuếch đại các tín hiệu gây cảm ứng TLR, và phân tử giống như kinase được kết hợp với thụ thể của Interleukin 1 (IRAK) (IRAK-M) làm giảm đáp ứng miễn dịch suốt quá trình mắc Melioidosis.
Các thụ thể túi viêm nội bào (intracellular inflammasome receptors_IIRs), đáng chú ý nhất, các thụ thể giống như nucleotide-binding oligomerization domain (NOD) (NLRs) NLRC4 và NLRP3, phát hiện các yếu tố độc của vi khuẩn và các tín hiệu nội sinh nguy hiểm, dẫn đến việc giải phóng interleukin-1β và interleukin-18 qua trung gian caspase 1, bên cạnh hiện tượng pyroptosis (chết tế bào lệ thuộc caspase làm hạn chế sự tăng trưởng vi khuẩn nội bào).
Interleukin-18 gây cảm ứng thêm nữa sự sản xuất interferon-γ có tính chất bảo vệ. Bạch cầu đa nhân trung tính được tuyển mộ hướng tới vị trí nhiễm khuẩn, và các dòng thác bổ thể và dòng thác đông máu bị hoạt hóa. Khi sự nhiễm khuẩn tiến triển, đáp ứng miễn dịch mắc phải dẫn đến sự tụ tập các tế bào T góp phần trong việc sản xuất interferon-γ, làm tăng đáp ứng miễn dịch trung gian tế bào và sản xuất kháng thể của các tế bào B.
Hầu hết dữ liệu trong mô hình này được bắt nguồn từ những nghiên cứu trong ống nghiệm và mô hình melioidosis trên động vật. Chết tế bào theo chương trình liên quan đến protein giống speck gồm vùng tuyển mộ caspase (ASC) được dùng như một phân tử thích ứng NLR, trái lại yếu tố 88 biệt hóa tế bào tủy (MyD88) được dùng như một phân tử thích ứng TLR trung tâm.

Hình 7
Nhận diện vi khuẩn B. pseudomallei & đáp úng miễn dịch
Các thụ thể nhận diện mẫu hình, đặc biệt là các thụ thể toll-like (TLRs) và các thụ thể giống như nucleotide-binding oligomerization domain (NOD) (NLRs), trước tiên là để phát hiện tác nhân gây bệnh vào vật chủ, khởi đầu các đáp ứng miễn dịch, và hình thành sự kết nối quan trọng giữa miễn dịch bẩm sinh và miễn dịch đáp ứng.
Các thụ thể của sự nhận diện hình mẫu phát hiện các yếu tố vận động được bảo tồn trong tác nhân gây bệnh được gọi là “các mẫu hình phân tử liên quan đến tác nhân gây bệnh” (PAMPs). B. pseudomallei biểu thị các PAMPs khác nhau, gồm lipopolysaccharide, peptidoglycan, flagella, TTSS, và DNA, mà được các TLRs khác nhau nhận diện, và các phân tử liên quan chẳng hạn như CD14 và MD2, mà có thể được điều hòa ngược ở bệnh nhân mắc melioidosis.
Các biến thể gene thuộc miền TLR4 ở người được kết hợp với tính nhạy cảm với melioidosis. Liệu rằng lipopolysaccharide của các tín hiệu B. pseudomallei bởi các phương tiện của TLR2, giống như lipopolysaccharide của Legionella pneumophila và Leptospira interrogans, hoặc các phương tiện của TLR4, mà liên quan như là thụ thể đối với lipopolysaccharide hay không vẫn còn là chủ đề nghiên cứu cần được quan tâm nhiều.

Hình 7
Điều thú vị, là chuột thiếu CD14 và thiếu TLR2 được gây cảm ứng Melioidosis thực nghiệm có một sức bảo vệ vật chủ được cải thiện đáng kể, mà được phản ánh qua một lợi ích sống sót mạnh mẽ, trái lại chuột thiếu TLR4 không thể phân biệt với chuột type hoang dã liên quan đến sự phát triển nhanh chóng và sống sót của vi khuẩn.
B. pseudomallei cũng có thể hoạt hóa túi viêm trong đại thực bào (cytosolic inflammasome), một phức protein, lớn đã hình thành, trong số các loại khác, bằng NLRs NLRC4 và NLRP3, sự đồng nhất của chúng dẫn đến sự hoạt hóa của caspase 1 và nâng cao sự chín muồi của các cytokines tiền viêm, interleukin-1β và interleukin-18.
Interleukin-18 đóng một vai trò bảo vệ suốt quá trình bệnh Melioidosis thông qua hiện tượng gây cảm ứng interferon-γ, một cytokine quan trọng mà góp phần sự bảo vệ chống lại melioidosis. Bằng việc so sánh, interleukin-1β có thể đóng một vai trò độc hại bằng cách gây ra sự tuyển mộ bạch cầu đa nhân trung tính quá nhiều và thương tổn mô và bằng ức chế sự hoạt hóa đối với việc sản xuất interferon-γ.
Sự hoạt hóa caspase 1 do B. pseudomallei gây cảm ứng thông qua NLRC4, một thụ thể đối với thành phần BsaK của TTSS3, dẫn đến đại thực bào chết một cách nhanh chóng, một tiến trình pyroptosis (chết tế bào lệ thuộc caspase hạn chế sự tăng trưởng vi khuẩn nội bào) được dùng như là một cơ chế đề kháng vật chủ nhằm hạn chế sự tăng trường của vi khuẩn ở nội bào.
Đáp ứng miễn dịch được bắt đầu bằng các thụ thể nhận diện mẫu hình dẫn đến sự tuyển mộ các bạch cầu đa nhân trung tính, đại thực bào, và các tế bào lympho hướng đến các vị trí nhiễm khuẩn. Mặc dầu sự tuyển mộ đa nhân trung tính không được tương hợp có thể là trở thành sự tàn phá, các bạch cầu đa nhân trung tính bị hoạt hóa đóng một vai trò quan trọng trong việc cản trở vi sinh vật sớm.

Hình 8
Các nghiên cứu chuột khiếm khuyết tế bào đã cho thấy rằng các tế bào T, đặc biệt là các tế bào TCD4+, góp phần quan trọng trong cả miễn dịch bẩm sinh lẫn miễn dịch mắc phải trong việc chống nhiễm B. pseudomallei, mặc dầu không có sự kết hợp giữa nhiễm HIV và nguy cơ mắc melioidosis. Các cytokines tiền viêm, TNF - α và IL - 6, cả hai cytokine này bị điều hòa nghịch trong quá trình melioidosis, hoạt hóa quá trình đông máu trong melioidosis nặng.
Tất cả 3 con đường chính bị liên quan đến, với việc nâng cao đồng thời các cơ chế tiền đông và bất thường các cơ chế kháng đông và các cơ chế tiêu fibrin. Hệ thống bổ thể, chịu trách nhiệm đối với việc bảo tồn ổn định nội môi của tế bào vật chủ và việc cố định vi khuẩn (opsonization) và việc loại trừ vi khuẩn, trở nên được hoạt hóa nhanh chóng và tiêu thụ nhanh chóng suốt quá trình nhiễm B. pseudomallei.

Hình 9
Cơ chế bệnh sinh
B. pseudomallei là một “tác nhân tình cờ”. Đó là những sinh vật có mặt trong môi trường mà không nhất thiết nhu cầu thông qua vật chủ trung gian để sinh trưởng và nhân lên.
Do các đặc điểm của vi khuẩn như thế đó, nên nhiễm bệnh ở người được xem như là điểm chết cuối cùng của sinh vật này (“dead end”).
Các chủng vi khuẩn này gây bệnh ở người thì khác so với các chủng gây bệnh ở động vật nhờ vàoviệc phân tích giải mã cấu trúc gen học của vi khuẩn. B. pseudomallei có thể xâm nhập vào trong các tế bào, tổng hợp các actin và lan rộng từ tế bào này sang tế bào khác, gây nên quá trình hợp nhất các tế bào với nhau và hình thànhcác tế bào khổng lồ đa nhân (multinucleate giant cell). B. pseudomallei là một trong những “proteobacteria” đầu tiên được xác định có chứa một hệ thống bài tiết type 6.
Vi khuẩn này còn được gọi là vi sinh vật duy nhất có khả năng chứa đến 6 hệ thống tiết độc lập với nhau. Chúng có khả năng gây bệnh ở người vì DNA nhận từ các vi sinh vật khác. Quá trình đột biến có tỷ lệ cao và vi sinh vật tiếp tục tiến triển sau khi nhiễm vào trong vật chủ.
B. pseudomallei có tính đề kháng nôi sinh với một số lượng lớn các tác nhân vi sinh vật khác. Một cơ chế quan trọng là chúng có khả năng bơm thuốc ra khỏi tế bào và điều này làm cầu nối trung gian cho kháng xảy ra với nhóm kháng sinh aminoglycosides (AmrAB - OprA), tetracyclines, fluoroquinolones và macrolides (BpeAB-OprB).

Hình 10
Triệu chứng lâm sàng
Melioidosis sơ bộ hay gặp ở những người thường tiếp xúc đều đặn với đất và nước. Nhiễm loài vi khuẩn này do xâm nhập qua da (ví dụ, có nghĩa một sự xâm nhập qua một thương tổn hoặc vết thương hở), hít phải (ví dụ, suốt mùa khí hậu khắc nghiệt hoặc do bất cẩn), hoặc nuốt phải (ví dụ, qua thực phẩm hoặc nước bị nhiễm)

Hình 11
Melioidosis có thể có một loạt các biểu hiện lâm sàng đa dạng, và mức độ nặng thay đổi từ một bệnh cảnh nhiễm khuẩn toàn thân bùng phát cấp tính đến một tình trạng nhiễm khuẩn mãn tính. Biểu thị các đường nhiễm (các ô xanh: xâm nhập qua da, xâm nhập do hít vào, và nuốt phải), các dạng lâm sàng (các ô đỏ: nhiễm không triệu chứng, nhiễm khuẩn máu, hoặc tái phản ứng của ổ nhiễm khu trú), và các biểu hiện đa dạng của bệnh (phần chữ không ô).
+ Phần A biểu thị thể bệnh Melioidosis da ở một vật chủ khỏe mạnh;
+ Phần B biểu thị các áp xe ở phổi trên phim chụp X- quang lồng ngực của bệnh nhân viêm phổi do bệnh Melioidosis cấp tính;
+ Phần C biểu thị hình ảnh phổi tương ứng với phim quét CT-scanner;
+ Phần D biểu thị các biểu hiện da ở một trường hợp tử vong do Melioidosis lan tỏa;
+ Phần E biểu thị áp xe lách trên phim quét CT-scanner bụng;
+ Phần F biểu thị mủ được hút ở một bệnh nhân áp xe tiền liệt tuyến;
+ Phần G biểu thị các áp xe trên một phim quét CT-scanner của một bệnh nhân.
Thời kỳ ủ bệnh của melioidosis đã được đánh giá ở một nghiên cứu duy nhất đã được công bố, trong đó 25% bệnh nhân đã nhớ lại một biến cố cụ thể chẳng hạn như một chấn thương đã biểu hiện lâm sàng 1 - 21 ngày (trung bình 9 ngày) sau đó. Liều nhiễm, tính độc của dòng vi khuẩn, kiểu nhiễm và các yếu tố nguy cơ ở vật chủ là toàn bộ các yếu tố góp phần thích hợp đối với thời kỳ ủ bệnh, biểu hiện lâm sàng và kết cục. Một thời kỳ ủ bệnh 1 ngày hoặc ít hơn đã được xác định sau khi hít phải B. pseudomallei trong một trường hợp gần như chết đuối (near - drowning), trái lại thời kỳ ủ bệnh dài nhất đã ghi nhận rõ ràng là 62 năm.
Nhiễm B. pseudomallei có những biểu hiện lâm sàng phong phú, và độ nghiêm trọng thay đổi từ một nhiễm khuẩn toàn thân bùng phát cấp tính đến một nhiễm khuẩn mãn tính (sự có mặt các triệu chứng > 2 tháng, minh chứng cho 11% tất cả trường hợp) mà có thể giống như ung thư hoặc lao. Trong một nghiên cứu mô tả 540 bệnh nhân ở vùng nhiệt đới Úc trên một thời kỳ 20 năm, có hình thái lâm sàng ban đầu là viêm phổi (51% bệnh nhân), tiếp đến là nhiễm khuẩn tiết niệu (14%), nhiễm khuẩn da (13%), nhiễm khuẩn máu không có ổ nhiễm khu trú (11%), viêm khớp nhiễm khuẩn hoặc viêm xương tủy (4%) và liên quan đến thần kinh (3%). Số còn lại 4% bệnh nhân không có bằng chứng nhiễm khuẩn khu trú.

Hình 12
Hơn 1/2 bệnh nhân biểu hiện nhiễm khuẩn máu, và sốc nhiễm khuẩn phát triển gần 1/5 số trường hợp. Các áp xe cơ quan nội tạng và các ổ nhiễm thứ phát ở phổi, khớp, hoặc cả hai thì hay gặp. Một biểu hiện khác biệt đáng lưu ý giữa các bệnh nhân ở miền nhiệt đới Úc và các bệnh nhân ở Đông nam Á là viêm tuyến mang tai sinh mủ, một bệnh cảnh có mặt lên đến 40% trường hợp do nhiễm Melioidosis ở trẻ em Thái Lan và Campuchia nhưng lại cực kỳ hiếm ở Úc.
Tại Úc, biểu hiện melioidosis ở tiền liệt tuyến chiếm gần 20% bệnh nhân nam và Melioidosis thần kinh với biểu hiện viêm thân não, thường có mặt liệt thần kinh sọ (đặc biệt là dây VII), hoặc biểu hiện viêm tủy với biểu hiện yếu thần kinh vận động ngoại vi.
Melioidosis tái phát xảy ra chừng 1/16 bệnh nhân, thường là năm đầu tiên sau lần biểu hiện lâm sàng lần đầu. Tính sơ bộ 1/4 trường hợp bệnh tái lại là do tái nhiễm, với số còn lại là do tái phát của một ổ nhiễm tồn tại dai dẵng. Tỷ lệ tử vong do Melioidosis gần 40% ở vùng đông bắc Thái Lan (35% ở trẻ em) và 14% ở Úc.
Thể bệnh Melioidosis ở người
Bệnh Melioidosis có thể phân loại như một bệnh nhiễm trùng cấp tính hoặc tại chỗ, nhiễm trùng phổi cấp tính, nhiễm trùng toàn bộ hệ tuần hoàn và nhiễm trùng lan tỏa. Thể nhiễm trùng chưa biểu hiện lâm sàng (sub-clinical infections) cũng có thể gặp. Thời gian ủ bệnh chưa thể xác định một cách rõ ràng, nhưng có thể dao động từ vài ngày đến nhiều năm; nói chung triệu chứng dường như xuất hiện 2-4 tuần sau khi tiếp xúc hoặc phơi nhiễm với mầm bệnh.
Mặc dù người khỏe mạnh có thể mắc bệnh Melioidosis, nhưng các yếu tố nguy cơ chính là đáo tháo đường, bệnh về gan, thận, thalassemia, và/ hoặc tình trạng suy gảm miễn dichj không liên quan đến HIV. Điều quan trọng là đáng chú ý đến bệnh Melioidosis thường được gọi “Kẻ bắt chước vĩ đại” ("The Great Mimicker") vì nó có một phổ lâm sàng đa dạng về hình thái biểu hiện rất dễ nhầm lẫn với một số bệnh khác như lao, viêm phổi. Về các thể bệnh, chúng ta có thể chia ra các thể như sau:

Hình 13
Thể tại chỗ hay cấp tính khu trú (acute, localized form)
Thể bênh này nói chung là khu trú như một vết loét, nốt hoặc abces da niêm do quá trình mầm bệnh xuyên qua da vào các vết thương sẵn có. Thể cấp tính của bệnh Melioidosis có thể biểu hiện sốt và đau cơ toàn thân. Bệnh có thể biểu hiện khu trú hoặc có thể diễn tiến nhanh chóng gây nhiễm trùng huyết.
Vi khuẩn đi vào da thông qua một vết rách hoặc vết trầy xước da và nhiễm trùng tại chỗ với các vết loét tiến triển. Thời gian ủ bệnh thường 1-5 ngày. Các tuyến hạch lympho sưng, vi khuẩn đi vào vật chủ thông qua niêm mạc có thể gây các tăng tiết nhầy tại các vùng bị ảnh hưởng.
Thể phổi (Pulmonary form/ lung infection)
Khi vi khuẩn đi vào bằng đường khí dung hoặc vào đường hô hấp thông qua hít phải lan rộng và nhiễm trùng phổi lan rộng. Viêm phổi, abces phổi và tràn dịch màng phổi có thể xảy ra. Thời gian ủ bệnh khoảng 10-14 ngày. Với bệnh melioidosis do hít phải, abces da có thể phát triểnvà mất vài tháng mới xuất hiện.
Khởi bệnh của thể phổi thường điển hình đi kèm bởi sốt cao, nhức đầu, chán ăn và đau mỏi cơ toàn thân. Đau ngực là hay gặp, nhưng có ho hoặc không ho có đờm là một dấu chỉ điểm có giá trị (hallmark) của thể này. Tổn thương khoang cũng có thể nhìn thấy trên phim chup X quang phổi tương tự như hình ảnh trong lao phổi.
Thể nhiễm trùng huyết (Septicemia/ bloodstream infection)
Khi vi khuẩn phát tán và di chuyển trong dòng máu của bệnh loét mũi thú y (glanders), thường tử vong trong vòng 7-10 ngày. Nhiễm trùng huyết phát triển và ảnh hưởng đến nhiều cơ quan, da, han, lách cũng có thể ảnh hưởng nghiêm trọng.
Với bệnh Melioidosis, nhiễm khuẩn huyết được quan sát trên các bệnh nhân nhiễm trùng có bệnh mạn tính. (ví dụ bệnh nhân HIV, đái tháo đường). Chúng có thể gây suy hô hấp, nhức đầu, sốt, tiêu chảy, tổn thương cơ qua chứa đầy mủ và abces lan tràn khắp các cơ quan. Nhiễm trùng huyết có thể rất nặng, với 90% tử vong xảy ra trong vòng 24-48 giờ.
Các bệnh nhân có các yếu tố nền sẵn có như đái tháo đường và suy thận thường có xu hướng diễn tiến đến hình thái lâm sàng này và thường dẫn đến hậu quả sốc nhiễm trùng. Các triệu chứng của nhiễm trùng huyết có thể là sốt, nhức đầu, suy hô hấp, đau bụng, đau khớp, mất định hướng,…Khởi đầu các triệu chứng thường rất nhanh và khối abces có thể nhìn thấy khắp cơ thể, đáng chú ý là gan, lách và tuyến tiền liệt.
Thể nhiễm trùng lan tỏa (Disseminated infection)
Bệnh Melioidosis lan tỏa là một bệnh nhiễm trùng biểu hiện với các ổ abces hình thành tại nhiều cơ quan khác nhau trong cơ thể. Có thể hoặc không liên quan đến nhiễm trùng. Các cơ quan liên quan thường điển hình là gan, phổi, lách và tuyến tiền liệt; liên quan đến các khớp, xương, phủ tạng, hệ lympho, da và não cũng có thể xảy ra.
Nhiễm trùng lan tỏa có thể nhìn thấy trong thể bệnh cấp và mạn tính. Các dấu chứng và triệu chứng còn có sốt, sụt cân, đau ngực, đau dạ dày, đau cơ, bắp thịt, nhức đầu và co giật.
Thể mạn tính (Chronic form)
Thể mạn tính liên quan đến đa ổ abces và ảnh hưởng đến nhiều cơ quan gan, lách, da, cơ. Thể này cũng được biết là bệnh lở ngứa ở ngựa và có thể tái hoạt nhiều năm sau khi nhiễm trùng tiên phát.

Hình 14
Phát hiện và chẩn đoán
Chẩn đoán bệnh Melioidosis được đánh giá thông qua soi kính hiển vi của các bệnh phẩm máu, nước tiểu, đờm hoặc mẫu da tại phòng xét nghiệm. Một xét nghiệm máu rất có ích để phát hiện sớm các trường hợp cấp tính của bệnh Melioidosis, nhưng không thể loại trừ bệnh nếu xét nghiệm âm tính. Các xét nghiệm thường dùng là: xét nghiệm kết dính hồng cầu gián tiếp (Indirect hemagglutination_IHA), xét nghiệm cố định bổ thể (complement fixation_CF) và phản ứng chuỗi trùng hợp (Polymerase chain reaction_PCR).
B. pseudomalleităng trưởng được trong các môi trường nuôi cấy đa dạng (thạch máu, thạch Mac Conkey, EMB,…). Môi trường nuôi cấy Ashdown (hoặc môi trường nuôi cấy Burkholderia cepacia) có thể được sử dụng để lựa chọn nuôi cấy đặc hiệu. Các mẻ nuôi cấy chủng chuyển dương tính trong 24 đến 48 giờ (dựa vào đặc tính tốc độ phát triển nhanh này người ta dùng để phân biệt với các vi khuẩn từ B. mallei - là các chủng phải cần ít nhất 72 giờ mới phát triển).
Hình 15
Đặc điểm khúm vi khuẩn là có nếp nhăn, xuất hiện ánh kim và có mùi đất hoặc mùi rễ cây (earthy odour). Nhuộm gram cho kết quả là trực khuẩn gram âm với đặc trưng ở hai đầu vi khuẩn có dạng vòng. Trong kiểm tra tính nhạy, hình như vi khuẩn biểu hiện khả năng kháng cao (kháng hoàn toàn với các thuốc kháng sinh, bao gồm cả loại colistin và gentamicin) và đó là đặc điểm để phân biệt với B. mallei - nó thì ngược lại nhạy một cách không rõ ràng với một số lượng lớn kháng sinh. Chỉ có những mẫu bệnh phẩm lấy từ trong môi trường, sự phân biệt với các chủng B. thailandensis không gây bệnh dựa vào thử nghiệm Arabinose là cần thiết (B. thailandensis không bao giờ được phân lập từ các mẫu bệnh phẩm lâm sàng).
Việc định loại vi khuẩn B. pseudomallei trong điều kiện phòng thí nghiệm có thể gặp khó khăn, đặc biệt là ở các quốc gia phương tây, nơi mà vi khuẩn B. pseudomallei rất hiếm nhìn thấy. Những khúm vi khuẩn có nếp nhăn lớn trông giống như là những chất gây nhiễm có trong môi trường và vì thế chúng thường bị loại bỏ và không có ý nghĩa lâm sàng.
Vi khuẩn này phát triển chậm hơn các vi khuẩn khác mà chúng cùng hiện diện trên cùng bệnh phẩm lâm sàng và trên những bệnh phẩm thu thập được từ những vị trí không vô trùng, thì vi khuẩn rất dễ phát triển tràn lan. Vì vậy, những mẫu bệnh phẩm lấy từ vùng không vô trùng nên được nuôi cấy trong môi trường chọn lọc (ví dụ như môi trường Ashdown hoặc môi trường dành cho nuôi cấy B. cepacia.
Chỉ khi việc phân lập được xem như là có ý nghĩa, thường phương pháp nhận định vi khuẩn được sử dụng có thể nhận dạng sai vi khuẩn với một số khác như Chromobacterium violaceum hoặc nhóm vi khuẩn gram âm không lên men khác như Burkholderia cepacia hoặc Pseudomonas aeruginosa. Ngược lại, bởi vì bệnh này hiếm thấy các khu vực các nước phương Tây, nên việc nhận dạng vi khuẩn B. pseudomallei trong môi trường nuôi cấy chưa thực sự coi trọng như tiếng chuông cảnh báo cho các bác sĩ chưa quen với bệnh này.

Hình 16
Các phương pháp sinh hóa thường quy để định loại vi khuẩn khác nhau nhiều: hệ thống API 20NE nhận dạng một cách chính xác B. pseudomallei trong 99% số ca, đây cũng là hệ thống tự động Vitek 1, nhưng phương pháp định loại tự động Vitek 2 chỉ nhận diện 19% trong tổng số ca được phân lập. Bệnh Melioidosis được chẩn đoán nhờ vào phân lập vi khuẩn Burkholderia pseudomallei từ máu, nước tiểu, đờm, vết thương ở da hoặc từ các tạng bị abces. Phát hiện và đo nồng độ kháng thể (Ab) chống lại vi khuẩn trong máu cũng rất hữu ích.
Một số xét nghiệm khác cũng góp phần không nhỏ vào trong xác định bệnh và các biến chứng đi kèm trong bệnh Melioidosis là công thức máu toàn phần, sinhhóa máu và nước tiểu về gan thận, tim mạch. Chụp X-quang phổi và điện tâm đồ, điện cơ là cần thiết trong những ca quá nặng đa biến chứng. Mô hình kháng thuốc với các thuốc diệt vi khuẩn thì được phân định rõ ràng và giúp để phân biệt các vi khuẩn với trực khuẩn mủ xanh P. aeruginosa.

Hình 17
Đa số các phân lập của B. pseudomallei thì kháng nội tại với tất cả thuốc kháng sinh nhóm aminoglycosides (thông qua cơ cơ chế bơm đẩy, nhưng lại nhạycảm với kháng sinh co-amoxiclav: mô hình kháng này hầu như chưa bao giờ xảy ra đối với vi khuẩn P. aeruginosa và điều này rất có ích trong việc định loại vi khuẩn.
Chẩn đoán bằng kỹ thuật PCR có thể thực hiện được, nhưng không thể làm thường quy trong chẩn đoán lâm sàng. Tại Thái Lan, phản ứng ngưng kết hạt latex được dùng rộng rãi để chẩn đoán. Kỹ thuật miễn dịch huỳnh quang phát hiện kháng thể cũng có giá trị và đang có sẵn trong một số ít trung tâm ở Thái Lan.
Cần lưu ý, nếu chẩn đoán chậm có thể gây tử vong, vì các chế độ kháng sinh trị liệu theo kinh nghiệm được dùng cho các trường hợp nghi ngờ nhiễm khuẩn toàn thân thường không bao phủ thỏa đáng đối với B. pseudomallei. Các hướng dẫn điều trị theo kinh nghiệm viêm phổi mắc phải tại cộng đồng ở các vùng dịch lưu hành khuyến cáo việc dùng các kháng sinh có hoạt tính chống lại B. pseudomallei ở các bệnh nhân có các yêu tố nguy cơ đối với melioidosis.
Việc nuôi cấy B. pseudomallei từ một mẫu nghiệm lâm sàng bất kỳ là hết sức cần thiết đối với chẩn đoán melioidosis. Các thủ thuật cận lâm sàng cho việc nuôi cấy và nhận diện B. pseudomallei tối ưu đã được phát triển, nhưng mọi sự chậm trể về nhận diện B. pseudomallei hoặc một sự nhận diện sai thành ra các loài khác không phải là hiếm gặp trong các phòng xét nghiệm mà ở đó chưa quen biết với vi khuẩn này. Một thử nghiệm phản ứng chuỗi (PCR) trực tiếp của một mẫu nghiệm lâm sàng có thể cung cấp một kết quả xét nghiệm nhanh hơn kết quả nuôi cấy, nhưng thử nghiệm này ít nhạy cảm, đặc biệt khi được thực hiện trên máu.
Kiểm định huyết thanh đơn thuần thì không thỏa đáng đối với việc xác minh chẩn đoán, đặc biệt ở trong các vùng bệnh lưu hành ở đó tỷ lệ huyết thanh (+) căn bản có thể > 50%. Nếu bắt đầu điều trị melioidosis và tiếp đến không phát hiện được B. pseudomallei trên các mẫu nghiệm nuôi cấy đầy đủ được lấy trước khi điều trị, thì nói chung người ta không khuyến cáo tiếp tục điều trị kháng sinh.
Thái độ xử trí ca bệnh
Hầu hết trường hợp Melioidosis có thể điều trị thành công bằng liệu pháp điều trị thích hợp. Burkholderia pseudomallei, loài vi khuẩn gây bệnh Melioidosis thường nhạy với các thuốc Ceftazidime, Imipenem, Meropenem, Doxycycline, Trimethoprim/sulfamethoxazole, Piperacillin, Amoxicillin-clavulanic acid, Azlocillin, Ticarcillin-clavulanate, Ceftriaxone, Aztreonam.
Melioidosis trải qua một quá trình có hại kéo dài; khó khăn điều trị dứt điểm nếu không có một quá trình dùng các kháng sinh kéo dài thích hợp. B. pseudomallei di truyền đề kháng với penicillin, ampicillin, các cephalosporin thế hệ 1 và 2, gentamicin, tobramycin, streptomycin, và polymyxin.
Trong số các kháng sinh mới hơn, ertapenem, tigecycline, và moxifloxacin có một hoạt tính trong ống nghiệm hạn chế chống lại các chủng B. pseudomallei trên lâm sàng và CMI đối với doripenem tương tự CMI đối với meropenem. Các cơ chế khác nhau đề kháng kháng sinh mắc phải đã từng được phát hiện, gồm các bơm đẩy thuốc ra (efflux pumps), bất hoạt enzyme, kháng sinh không thể thấm qua màng vi khuẩn, các thay đổi về vị trí đích tác dụng kháng sinh, và các thay đổi amino acid ở penA, mã hóa gene lớp A β-lactamase được bảo tồn cao. Về nguyên tắc điều trị, nên tuân thủ:
1.Điều trị nên bắt đầu sớm khi phát hiện ra bệnh vì bệnh Melioidosis có thể tiến triển ra các thể nặng hơn và thậm chí có thể tử vong, lệ thuộc vào nhiều yếu tố nguy cơ ảnh hưởng lên khả năng tự cơ thể chống lại bệnh này.
2.Loại nhiễm trùng và liệu trình điều trị sẽ tác động lên kết quả điều trị về lâu dài. Nói chung, điều trị nên bắt đầu sớm với liệu pháp kháng sinh truyền tĩnh mạch trong vòng 10-14 ngày, và theo sau là liệu pháp đường uống 3-6 tháng.
3.Việc điều trị bệnh Melioidosis liên quan đến các kháng sinh và lệ thuộc vào vị trí thương tổn cũng như từng thể của bệnh.
4.Đối với các bệnh nhân bệnh biểu hiện nhẹ, Trung tâm Phòng chống bệnh tật Mỹ (US.CDC) huyên dùng kháng sinh Imipenem, Penicillin, Doxycycline, Amoxicillin-Clavulanic acid, Ceftazidime, Ticarcillin-clavulanic acid, Ceftriaxone, Aztreonam.
5.Các bênh nhân bị nặng, nghiêm trọng thì dùng thuốc phối hợp từ 2 đến 12 tháng.
6.Với các thể liên quan đến phổi của bệnh Melioidosis, nếu nuôi cấy vẫn còn dương tính trong 6 tháng, đề nghị phẩu thuật loại bỏ khối abces phổi thông qua cắt thùy phổi.
Bảng 1. Các khuyến cáo điều trị bệnh Melioidosis
Điều trị cấp cứu tích cực ban đầu (kéo dài ≥ 14 ngày) HOẶC |
Ceftazidime | 50mg/kg đến 2g | Mỗi 6 giờ |
Meropenem | 25mg/ kg đến 1g | Mỗi 8 giờ |
Imipenem | 25mg/kg đến 1g | Mỗi 6 giờ |
Trimethprime - Sulfamethoxazole | 8 + 40mg/kg đến 320 + 1600mg/kg | Mỗi 12 giờ |
Điều trị loại bỏ/ tiệt căn (kéo dài ≥ 3 tháng) VÀ LỰA CHỌN TỐI ƯU |
Trimethprime - Sulfamethoxazole | 8 + 40mg/kg đến 320 + 1600mg/kg | Mỗi 12 giờ |
Doxycycline | 2mg/kg đến 100mg | Mỗi 12 giờ |
Điều trị bệnh Melioidosis gồm 2 giai đoạn:
+ Giai đoạn điều trị tấn công hay điều trị tích cực (intensive phase) ít nhất 10-14 ngày với các kháng sinh ceftazidime, meropenem, hoặc imipenem được dùng bằng đường tĩnh mạch;
+ Giai đoạn điều trị tiệt căn (eradication therapy) bằng kháng sinh đường uống, thường với trimethoprim - sulfamethoxazole (TMP-SMX) kéo dài 3-6 tháng.
Bảng 2. Thuốc điều trị hai giai đoạn của bệnh Melioidosis*
Kháng sinh | Liều lượng |
Điều trị khởi đầu mạnh ☼ |
Ceftazidime | 50 mg/kg (lên đến 2 g), 3 – 4 lần/ngày |
Meropenem | 25 mg/kg (lên đến 1 g), 3 lần/ngày |
Imipenem | 25 mg/kg (lên đến 1 g), 4 lần/ngày |
Điều trị đường uống tận gốc β |
TMP – SMX | |
Trọng lượng cơ thể |
> 60 kg | 2 x 160 mg TMP - 800 mg SMX(viên 960 mg), mỗi 12 giờ/lần |
40 - 60 kg | 3 x 80 mg TMP - 400 mg SMX(viên 480 mg), mỗi 12 giờ/lần |
< 40 kg, người lớn | 1 x 160 mg TMP - 800 mg SMX(viên 960mg) hoặc 2 x 80 mg TMP - 400 mg SMX(viên 480mg), mỗi 12 giờ/lần |
< 40 kg, trẻ em | 8 mg TMP/kg - 40 mg SMX/kg, mỗi 12 giờ |
* Thông tin liều thuốc từ Peacock và cộng sự và Chetchotisakd và cộng sự.
☼ Định nghĩa điều trị mạnh khi dùng một trong những thuốc được liệt kê bằng đường tĩnh mạch trong một thời kỳ 10-14 ngày. Bốn hoặc trên 4 tuần điều trị đường tĩnh mạch có thể cần thiết cho các trường hợp bệnh nặng (ví dụ, những người tiếp tục sốc nhiễm khuẩn, các ổ áp xe định vị các nơi sâu hoặc cơ quan, bệnh phổi lan tỏa, viêm khớp nhiễm khuẩn, viêm xương tủy, hoặc melioidosis thần kinh). Bên cạnh TMP - SMX có sẵn với tỷ số liều thuốc cố định là 1 phần TMP với 5 phần SMX, tại liều 8 mg TMP và 40 mg SMX đối với mỗi kg cân nặng cơ thể (lên đến 320 mg TMP và 1.600 mg SMX) mỗi 12 giờ phải được cân nhắc cho bệnh nhân bị mắc melioidosis thần kinh, tuyến tiền liệt, xương, hoặc khớp. Một sự chuyển qua dùng meropenem được chỉ định nếu tình trạng lâm sàng xấu đi khi dùng ceftazidime (ví dụ, xuất hiện suy cơ quan), nếu một ổ nhiễm mới xuất hiện trong quá trình điều trị, hoặc cấy máu lại có kết quả (+) sau 7 ngày.
β Điều trị bằng đường uống được yêu cầu trong thời gian 3-6 tháng. Nếu vi khuẩn đề kháng với TMP - SMX hoặc bệnh nhân không thể chịu đựng các tác dụng ngoại ý trong việc đáp ứng với thuốc, chọn lựa thuốc thứ 2 là amoxicillin-clavunate và doxycyclline. Liều amoxicilline - clavunate được khuyến cáo 20 mg amoxicillin và 5 mg clavunate mỗi kg cân nặng được dùng bằng đường uống, 3 lần/ngày.
Carbapenems, như Meropenem và Imipenem, có nồng độ ức chế tối thiểu thấp hơn và các kết quả cao trong các nghiên cứu thời gian, diệt khuẩn trong ống nghiệm hơn ceftazidime, nhưng trong một nghiên cứu ngẫu nhiên so sánh ở Thái Lan đã không thấy được một lợi ích sống còn của imipenem hơn ceftazidime. Khuyến cáo hiện nay đối với giai đoạn điều trị bằng đường uống là TMP - SMX, khuyến cáo này thay thế cho khuyến cáo trước đây để cho dùng thuốc này kết hợp với doxycycline. Khuyến cáo sự tìm kiếm cẩn thận đối với các áp xe cơ quan nội tạng, chẳng hạn như việc dùng CT để quét hoặc siêu âm ổ bụng và khung chậu. Điều trị thêm vào đối với các ổ áp xe gồm dẫn lưu các ổ mủ và chọc hút và rửa các ổ khớp bị nhiễm khuẩn.
Tỷ lệ kháng đối với TMP - SMX, như được đánh giá với việc dùng Etest (AB Biodisk), được báo cáo xấp xỉ 13% đối với các chủng được phân lập tại Thái Lan nhưng thấp hơn nhiều đối với các chủng được phân lập ở Úc (0-2,5%). Một thuốc thay thế để điều trị tiệt căn (eradication) là amoxicillin -clavulanate; mặc dầu hiệu lực của nó thấp hơn TMP- SMX vì nó được kết hợp với một tỷ lệ tái phát cao hơn, amoxicillin – clavulanic acid được dùng ở một số địa phương dành cho trẻ em và thai phụ. B. pseudomallei đề kháng với carbapenems chưa có tư liệu minh chứng, và sơ bộ đề kháng với ceftazidime là cực kỳ hiếm gặp.
Trong các trường hợp rất hiêm, sự đề kháng mắc phải đối với ceftazidime xảy ra trong quá trình điều trị; các cơ chế đối với đề kháng mắc phải gồm các đột biến điểm và và sự khiếm khuyết gene.
Phòng bệnh
Melioidosis là một bệnh có thể có tiềm năng phòng ngừa, nhưng chưa có cơ sở bằng chứng để phát triển các hướng dẫn phòng ngừa. Mặc dầu người ta khuyến cáo rằng người mắc chứng xơ hóa nang được cảnh báo về việc đi du lịch đến các vùng ở đó melioidosis đang lưu hành, nói chung người ta không có lời khuyên đối với các du khách, cho dù số lượng trường hợp bệnh đã tăng lên đối với các du khách, nhiều người trong số họ mắc bệnh đái tháo đường.
Người ta khuyên những người có nhiều yếu tố nguy cơ chẳng hạn như đái tháo đường hoặc trị liệu bằng thuốc ức chế miễn dịch nên ở nhà suốt thời kỳ mưa gió nặng, lúc đó bụi có thể mang B. pseudomallei.
Chưa có bằng chứng để hỗ trợ cho việc bệnh lây từ người sang người qua đường hô hấp. Hiện nay, chưa có vaccine đặc hiệu phòng bệnh Melioidosis, nhưng đây là một lãnh vực nghiên cứu tích cực trên các mô hình động vật liên quan đến việc sử dụng vaccine dự tuyển sống giảm độc lực, tiểu đơn vị, DNA trên căn bản plasmid, và vaccine dự tuyển vi khuẩn đã bị diệt hoàn toàn. Chưa có vaccine dự tuyển đã từng được kết hợp với tính sinh miễn dịch làm vô khuẩn.
Các khuyến cáo đối với dự phòng sau phơi nhiễm sau phơi nhiễm ở phòng thí nghiệm do bất cẩn đối với B. pseudomallei hoặc trong biến cố tai nạn giải phóng B. pseudomallei. Melioidosis đã từng được báo cáo sau ghép thận và việc phát hiện đang tăng lên ở các bệnh nhân tiếp nhận thuốc điều trị ức chế miễn dịch, đặc biệt glucocorticoids liều cao.
Việc tiếp cận với điều trị bệnh nhân bị ức chế miễn dịch là khi bắt đầu trị liệu ức chế miễn dịch và không triệu chứng nhưng có bằng chứng phơi nhiễm về huyết thanh. Nhìn chung, nhờ cải thiện chẩn đoán vi sinh và việc chú ý đến bệnh của nhân viên y tế, việc phát hiện và báo cáo trường hợp Melioidosis ngày càng tăng trên thế giới.
So sánh với Úc, tỷ lệ tử vong ở Thái Lan cao hơn, gợi ý rằng những cố gắng để giảm tỷ lệ tử vong phải được hướng đến những nơi mà nguồn nhân lực bị hạn chế, với một nhấn mạnh đến việc dùng kháng sinh sớm, phát hiện nhiễm khuẩn toàn thân sớm và hồi sức dịch thỏa đáng. Việc giảm thiểu thêm nữa tỷ lệ tử vong ở các khu vực còn thiếu thốn cơ sở vật chất y tế hiện đại và việc cải thiện có thể chỉ còn một cách là tùy thuộc vào chiến lược điều trị mới từ nghiên cứu cơ bản về bệnh sinh vi khuẩn và các tương tác giữa tác nhân gây bệnh, vật chủ.
Tài liệu tham khảo
1.Stanton AT, Fletcher W (1921). "Melioidosis, a new disease of the tropics". Far Eastern Association of Tropical Medicine: Transactions of the Fourth Congress. Batavia, Dutch East Indies: Javasche Boekhandel en Drukkerij.
2.A J Simpson; Suputtamongkol Y; Smith MD; et al. (1999). "Comparison of imipenem and ceftazidime as therapy for severe melioidosis". Clinical Infectious Diseases. 29 (2): 381–387. doi:10.1086/520219. PMID 10476746.
3.Ngauy V, Lemeshev Y, Sadkowski L, Crawford G (2005). "Cutaneous Melioidosis in a Man Who Was Taken as a Prisoner of War by the Japanese during World War II". Journal of Clinical Microbiology Microb. 43 (2): 970–972. doi:10.1128/JCM.43.2.970-972.2005. PMC 548040 . PMID 15695721.
4.Centers for Disease Control and Prevention. Melioidosis. 2012. Accessed February 27, 2017.
5.Apisarnthanarak A, Apisarnthanarak P, Mundy LM (2006). "Computer tomography characteristics of Burkholderia pseudomallei liver abscess". Clinical Infectious Diseases. 42 (7): 989–993. doi:10.1086/501017. PMID 16511765.
6.Laopaiboon V, Chamadol N, Buttham H, Sukeepaisarnjareon W (2009). "CT findings of liver and splenic abscesses in melioidosis: comparison with those in non-melioidosis". Journal of the Medical Association of Thailand. 92 (11): 1476–1484. PMID 19938740.
7.Dance DA, Davis TM, Wattanagoon Y, et al. (1989). "Acute suppurative parotitis caused by Pseudomonas pseudomallei in children". Journal of Infectious Diseases. 159 (4): 654-660. doi:10.1093/infdis/159.4.654. PMID 2926159.
8.Raja, NS; Ahmed MZ; Singh NN (1 April 2005). "Melioidosis: an emerging infectious disease". Journal of Postgraduate Medicine. 51 (2): 140–145. PMID 16006713.
9.Chlebicki, MP; Tan BH (2006). "Six cases of suppurative lymphadenitis caused by Burkholderia pseudomallei infection". Transactions of the Royal Society of Tropical Medicine and Hygiene. 100 (8): 798–801. doi:10.1016/j.trstmh.2005.10.004. PMID 16542691.
10.Currie BJ, Fisher DA, Howard DM, et al. (2000). "Endemic melioidosis in tropical northern Australia: a 10-year prospective study and review of the literature". Clinical Infectious Diseases. 31 (4): 981–986. doi:10.1086/318116. PMID 11049780.
11.Falade OO, Antonarakis ES, Kaul DR, Saint S, Murphy PA (2008). "Clinical problem-solving. Beware of first impressions". New England Journal of Medicine. 359 (6): 628–634. doi:10.1056/NEJMcps0708803. PMID 18687644.
12.Chetchotisakd, P; Anunnatsiri, S; Kiatchoosakun, S; Kularbkaew, C (2010). "Melioidosis pericarditis mimicking tuberculous pericarditis". Clinical Infectious Diseases. 51 (5): e46–49. doi:10.1086/655699. PMID 20645861.
13.Suntornsut P, Kasemsupat K, Silairatana S, et al. (2013). "Prevalence of Melioidosis in Patients with Suspected Pulmonary Tuberculosis and Sputum Smear Negative for Acid-Fast Bacilli in Northeast Thailand". American Journal of Tropical Medicine and Hygiene. 89 (5): 983–985. doi:10.4269/ajtmh.13-0286. PMC 3820347 . PMID 24062474.
14.Ngauy V, Lemeshev Y, Sadkowski L, Crawford G (2005). "Cutaneous Melioidosis in a Man Who Was Taken as a Prisoner of War by the Japanese during World War II". Journal of Clinical Microbiology. 43 (2): 970–972. doi:10.1128/JCM.43.2.970-972.2005. PMC 548040 . PMID 15695721.
15.Wuthiekanun V, Suputtamongkol Y, Simpson AJ, Kanaphun P, White NJ (2001). "Value of Throat Swab in Diagnosis of Melioidosis". Journal of Clinical Microbiology. 39 (10): 3801–3802. doi:10.1128/JCM.39.10.3801-3802.2001. PMC 88440 . PMID 11574624.
16.Limmathurotsakul D, Wuthiekanun V, Chierakul W, et al. (2005). "Role and Significance of Quantitative Urine Cultures in Diagnosis of Melioidosis". Journal of Clinical Microbiology. 43 (5): 2274–2276. doi:10.1128/JCM.43.5.2274-2276.2005. PMC 1153798 . PMID 15872255.
17.Dance DA, White NJ, Suputtamongkol Y, Wattanagoon Y, Wuthiekanun V, Chaowagul W (1990). "The use of bone marrow culture for the diagnosis of melioidosis". Transactions of the Royal Society of Tropical Medicine and Hygiene. 84 (4): 585–587. doi:10.1016/0035-9203(90)90050-O. PMID 2091358.
18.Peacock SJ, Chieng G, Cheng AC, et al. (2005). "Comparison of Ashdown's Medium, Burkholderia cepacia Medium, and Burkholderia pseudomallei Selective Agar for Clinical Isolation of Burkholderia pseudomallei". Journal of Clinical Microbiology. 43 (10): 5359–5361. doi:10.1128/JCM.43.10.5359-5361.2005. PMC 1248505 . PMID 16208018.
19.Francis A, Aiyar S, Yean C, Naing L, Ravichandran M (2006). "An improved selective and differential medium for the isolation of Burkholderia pseudomallei from clinical specimens". Diagnostic Microbiology and Infectious Diseases. 55 (2): 95–99. doi:10.1016/j.diagmicrobio.2005.11.008. PMID 16626918.
20.Puthucheary SD, Anuar AS, Tee TS (2010). "Burkholderia thailandensis whole cell antigen cross-reacts with B. pseudomallei antibodies from patients with melioidosis in an immunofluorescent assay". The Southeast Asian Journal of Tropical Medicine and Public Health. 41 (2): 397-400. PMID 20578523.
21.Limmathurotsakul D, Chantratita N, Teerawattanasook N, et al. (2011). "Enzyme-Linked Immunosorbent Assay for the Diagnosis of Melioidosis: Better Than We Thought". Clinical Infectious Diseases. 52 (8): 1024–1028. doi:10.1093/cid/cir080. PMC 3070030 . PMID 21460318.
22.Peacock SJ, Cheng AC, Currie BJ, Dance DA (2011). "The Use of Positive Serological Tests as Evidence of Exposure to Burkholderia pseudomallei". American Journal of Tropical Medicine and Hygiene. 84 (6): 1021–1022. doi:10.4269/ajtmh.2011.11-0114a. PMC 3110358 . PMID 21633045.
23.Lim KS, Chong VH (2010). "Radiological manifestations of melioidosis". Clinical Radiology. 65 (1): 66–72. doi:10.1016/j.crad.2009.08.008. PMID 20103424.
24.Muttarak M, Peh WC, Euathrongchit J, Lin SE, Tan AG, Lerttumnongtum P, Sivasomboon C (2008). "Spectrum of imaging findings in melioidosis". British Journal of Radiology. 82 (978): 514–521. doi:10.1259/bjr/15785231. PMID 19098086.
25.White NJ, Dance DA, Chaowagul W, et al. (1989). "Halving of mortality of severe melioidosis by ceftazidime". Lancet. 2 (8665): 697–701. doi:10.1016/S0140-6736(89)90768-X. PMID 2570956.
26.Chierakul W, Anunnatsiri S, Chaowagul W, et al. (2007). "Addition of trimethoprim-sulfamethoxazole to ceftazidime during parenteral treatment of melioidosis is not associated with a long-term outcome benefit". Clinical Infectious Diseases. 45 (4): 521–523. doi:10.1086/520010. PMID 17638209.
27.Cheng AC, Fisher DA, Anstey NM, et al. (2004). "Outcomes of Patients with Melioidosis Treated with Meropenem". Antimicrob Agents Chemother. 48 (5): 1763–65. doi:10.1128/AAC.48.5.1763-1765.2004. PMC 400582 . PMID 15105132.
28.Chetchotisakd P, Porramatikul S, Mootsikapun P, Anunnatsiri S, Thinkhamrop B (2001). "Randomized, double-blind, controlled study of cefoperazone-sulbactam plus cotrimoxazole versus ceftazidime plus cotrimoxazole for the treatment of severe melioidosis". Clinical Infectious Diseases. 33 (1): 29–33. doi:10.1086/320878. PMID 11389491.
29.Dance DA, Wuthiekanun V, White NJ, Chaowagul W (1988). "Antibiotic resistance in Pseudomonas pseudomallei". Lancet. 1 (8592): 994–995. doi:10.1016/S0140-6736(88)91810-7. PMID2896855.
30.Suputtamongkol Y, Rajchanuwong A, Chaowagul W, et al. (1994). "Ceftazidime vs. amoxicillin/clavulanate in the treatment of severe melioidosis". Clinical Infectious Diseases. 19 (5): 846–853. doi:10.1093/clinids/19.5.846. PMID 7893868.
31.University of Oxford (18 December 2007). "A randomized double blinded comparison of ceftazidime and meropenem in severe melioidosis (ATOM)". ClinicalTrials.gov. National Institutes of Health. Retrieved 27 Jan 2011.
32.Simpson, A. J. H.; Opal, S. M.; Angus, B. J.; Prins, J. M.; Palardy, J. E.; Parejo, N. A.; Chaowagul, W.; White, N. J. (2000). "Differential antibiotic-induced endotoxin release in severe melioidosis". Journal of Infectious Diseases. 181 (3): 1014–1019. doi:10.1086/315306. PMID 10720525.
33.Bilgrami, I.; Roberts, J. A.; Wallis, S. C.; Thomas, J.; Davis, J.; Fowler, S.; Goldrick, P. B.; Lipman, J. (2010). "Meropenem Dosing in Critically Ill Patients with Sepsis Receiving High-Volume Continuous Venovenous Hemofiltration". Antimicrobial Agents and Chemotherapy. 54 (7): 2974–2978. doi:10.1128/AAC.01582-09. PMC 2897321 . PMID 20479205.
34.Shih H-I; Chuang Y-C; Cheung BM-H; et al. (February 2008). "Sporadic and outbreak cases of melioidosis in southern Taiwan: clinical features and antimicrobial susceptibility". Infection. 37 (1): 9–15. doi:10.1007/s15010-008-7324-8. PMID 18854938.
35.Harris P, Engler C, Norton R (2011). "Comparative in vitro susceptibility of Burkholderia pseudomallei to doripenem, ertapenem, tigecycline and moxifloxacin". International Journal of Antimicrobia Agents. 37 (6): 547–549. doi:10.1016/j.ijantimicag.2011.02.001.
36.Thamlikitkul V, Trakulsomboon S (2010). "In vitro activity of biapenem against Burkholderia pseudomallei". International Journal of Antimicrobia Agents. 35 (5): 514. doi:10.1016/j.ijantimicag.2010.01.002. PMID 20188524.
37.Cheng AC, Limmathurotsakul D, Chierakul W, et al. (2007). "A randomized controlled trial of granulocyte colony-stimulating factor for the treatment of severe sepsis due to melioidosis in Thailand". Clinical Infectious Diseases. 45 (3): 308–314. doi:10.1086/519261. PMID 17599307.
38.Chierakul W, Anunnatsiri S, Short JM, et al. (2005). "Two randomized controlled trials of ceftazidime alone versus ceftazidime in combination with trimethoprim-sulfamethoxazole for the treatment of severe melioidosis". Clinicl Infectious Diseases. 41 (8): 1105–1113. doi:10.1086/444456. PMID 16163628.
39.Chierakul W, Anunnatsiri S, Chaowagul W, Peacock SJ, Chetchotisakd P, Day NP (2007). "Addition of trimethoprim-sulfamethoxazole to ceftazidime during parenteral treatment of melioidosis is not associated with a tong-term outcome benefit". Clinical Infectious Diseases. 45 (4): 521–523. doi:10.1086/520010. PMID 17638209.
40.Chaowagul W, Simpson AJ, Suputtamongkol Y, et al. (1999). "A comparison of chloramphenicol, trimethoprim-sulfamethoxazole, and doxycycline with doxycycline alone as maintenance therapy for melioidosis". Clinical Infectious Diseases. 29 (2): 375–380. doi:10.1086/520218. PMID 10476745.
41.Rajchanuvong A, Chaowagul W, Suputtamongkol Y, Smith MD, Dance DA, White NJ (1995). "A prospective comparison of co-amoxiclav and the combination of chloramphenicol, doxycycline, and co-trimoxazole for the oral maintenance treatment of melioidosis". Transactions of the Royal Society of Tropical Medicine and Hygiene. 89 (5): 546–549. doi:10.1016/0035-9203(95)90104-3. PMID 8560537.
42.Cheng AC, Chierakul W, Chaowagul W, et al. (2008). "Short Report: Consensus Guidelines for Dosing of Amoxicillin-Clavulanate in Melioidosis". American Journal of Tropical Medicine and Hygiene. 78 (2): 208–209. PMC 3034162 . PMID 18256414.
43.Chaowagul W, Supputtamongkul Y, Smith MD, White NJ (1997). "Oral fluoroquinolones for maintenance treatment of melioidosis". Transactions of the Royal Society of Tropical Medicine and Hygiene. 91 (5): 599–601. doi:10.1016/S0035-9203(97)90044-4. PMID 9463680.
44.Chetchotisakd P, Chaowagul W, Mootsikapun P, Budhsarawong D, Thinkamrop B (Jan–Feb 2001). "Maintenance therapy of melioidosis with ciprofloxacin plus azithromycin compared with cotrimoxazole plus doxycycline". American Journal of Tropical Medicine and Hygiene. 64 (1–2): 24–27. PMID 11425157.
45.Chaowagul W,; Simpson, Andrew J. H.; Suputtamongkol, Yupin; Smith, Michael D.; Angus, Brian J.; White, Nicholas J. (August 1999). "Clin Infect Dis". Clinical Infectious Diseases. 29 (2): 375–380. doi:10.1086/520218. PMID 10476745.
46.Limmathurotsakul D; Chaowagul W; Chierakul Wirongrong; et al. (2006). "Risk factors for recurrent melioidosis in Northeastern Thailand". Clinical Infectious Diseases. 43 (8): 979–986. doi:10.1086/507632. PMID 16983608.
47.Dance DA, Wuthiekanun V, Chaowagul W, White NJ (1989). "Interactions in vitro between agents used to treat melioidosis". Journal of Antimicrobial Chemotherapy. 24 (3): 311–316. doi:10.1093/jac/24.3.311. PMID 2681117.
48.Chetchotisakd, P; Chierakul, W; Chaowagul, W; Anunnatsiri, S; Phimda, K; Mootsikapun, P; Chaisuksant, S; Pilaikul, J; Thinkhamrop, B; Phiphitaporn, S; Susaengrat, W; Toondee, C; Wongrattanacheewin, S; Wuthiekanun, V; Chantratita, N; Thaipadungpanit, J; Day, NP; Limmathurotsakul, D; Peacock, SJ (1 March 2014). "Trimethoprim-sulfamethoxazole versus trimethoprim-sulfamethoxazole plus doxycycline as oral eradicative treatment for melioidosis (MERTH): a multicentre, double-blind, non-inferiority, randomised controlled trial". Lancet. 383 (9919): 807–814. doi:10.1016/S0140-6736(13)61951-0. PMC 3939931 . PMID 24284287.
49.Cheng AC, McBryde ES, Wuthiekanun V, Chierakul W, Amornchai P, Day NP, Peacock SJ (2009). "Dosing Regimens of Cotrimoxazole (Trimethoprim-Sulfamethoxazole) for Melioidosis". Antimicrobial Agents and Chemotherapy. 53 (10): 4193–4199. doi:10.1128/AAC.01301-08. PMC 2764189 . PMID 19620336.
50.TJ Inglis; CL Golledge; A Clair; J Harvey (2001). "Case report: recovery from persistent septicemic melioidosis". American Journal of Tropical Medicine and Hygiene. 65 (1): 76–82. PMID 11504412.
51.Dance DA, Wuthiekanun V, Chaowagul W, White NJ (1989). "Interactions in vitro between agents used to treat melioidosis". Journal of Antimicrobial Chemotherapy. 24 (3): 311–316. doi:10.1093/jac/24.3.311. PMID2681117.
52.Couture E (1935). "La Melioidosis Etat actuel de la question". Rev Hyg Méd Prèv. 57: 190.
53.Warner JM, Pelowa DB, Currie BJ, Hirst RG (2007). "Melioidosis in a rural community of Western Province, Papua New Guinea". Transactions of the Royal Society of Tropical Medicine and Hygiene. 101 (8): 809–813. doi:10.1016/j.trstmh.2007.02.024. PMID 17499321.
54.White NJ (2003). "Melioidosis". Lancet. 361 (9370): 1715–1722. doi:10.1016/S0140-6736(03)13374-0. PMID 12767750.
55.Chaowagul W, White NJ, Dance DA, et al. (1989). "Melioidosis: a major cause of community-acquired septicemia in northeastern Thailand". Journal of Infectious Diseases. 159 (5): 890–899. doi:10.1093/infdis/159.5.890. PMID 2708842.
56.Sarovich DS, Ward L, Price EP, et al. (2014). "Recurrent melioidosis in the Darwin Prospective Melioidosis Study: improving therapies mean that relapse cases are now rare". Journal of Clinical Microbiology. 52 (2): 650–653. doi:10.1128/JCM.02239-13. PMC 3911345 . PMID 24478504.
57.Maharjan B, Chantratita N, Vesaratchavest M, et al. (2005). "Recurrent Melioidosis in Patients in Northeast Thailand Is Frequently Due to Reinfection Rather than Relapse". Journal of Clinical Microbiology. 43 (12): 6032–6034. doi:10.1128/JCM.43.12.6032-6034.2005. PMC 1317219 . PMID 16333094.
58.Chaowagul W, Suputtamongkol Y, Dance DA, Rajchanuvong A, Pattara-arechachai J, White NJ (1993). "Relapse in melioidosis: incidence and risk factors". Journal of Infectious Diseases. 168 (5): 1181–1185. doi:10.1093/infdis/168.5.1181. PMID 8228352.
59.Holland DJ, Wesley A, Drinkovic D, Currie BJ (2002). "Cystic fibrosis and Burkholderia pseudomallei infection: an emerging problem?". Clinical Infectious Diseases. 35 (12): e138–140. doi:10.1086/344447. PMID 12471591.
60.McCormick J B (1975). "Human-to-human transmission of Pseudomonas pseudomallei". Annals of Internal Medicine. 83 (4): 512–513. doi:10.7326/0003-4819-83-4-512.
61.Kunakorn M, Jayanetra P, Tanphaichitra D (1991). "Man-to-man transmission of melioidosis". Lancet. 337 (8752): 1290–1291. doi:10.1016/0140-6736(91)92962-2. PMID 1674089.
62.Centers for Disease Control and Prevention (2009). Biosafety in Microbiological and Biomedical Laboratories (5th ed.). Atlanta, Georgia: National Institutes of Health.
63.Sivalingam SP, Sim SH, Jasper LC, et al. (2008). "Pre- and post-exposure prophylaxis of experimental Burkholderia pseudomallei infection with doxycycline, amoxicillin/clavulanic acid and co-trimoxazole". Journal of Antimicrobial Chemotherapy. 61 (3): 674–678. doi:10.1093/jac/dkm527. PMID 18192684.
64.Peacock SJ, Schweizer HP, Dance DA, et al. (2008). "Management of Accidental Laboratory Exposure to Burkholderia pseudomallei and B. mallei". Emerging Infectious Diseases. 14 (7): e2. doi:10.3201/eid1407.071501. PMC 2600349 . PMID 18598617.
65.Kenny DJ, Sefton AM, Brooks TJ, Laws TR, Simpson AJ, Atkins HS (2010). "Evaluation of azithromycin, trovafloxacin and grepafloxacin as prophylaxis for experimental murine melioidosis". International Journal of Antimicrobial Agents. 36 (1): 87–89. doi:10.1016/j.ijantimicag.2010.03.019. PMID 20462743.
66.Cheng, A. C., & Currie, B. J. (2005). Melioidosis: Epidemiology, Pathophysiology, and Management. Clinical Microbiology Reviews, 18(2), 383–416. http://doi.org/10.1128/CMR.18.2.383-416.2005
67.CDC Disease Info melioidosis
68.Withers MR (ed.) (2014). USAMRIID's Medical Management of Biological Casualties Handbook (PDF) (8th ed.). Fort Detrick, Maryland: U.S. Army Medical Institute of Infectious Diseases. p. 53.
69.V Vuddhakul; et al. (1999). "Epidemiology of Burkholderia pseudomallei in Thailand". American Journal of Tropical Medicine and Hygiene. 60 (3): 458–461.
70.Wuthiekanun V, Mayxay M, Chierakul W, Phetsouvanh R, Cheng AC, White NJ, Day NP, Peacock SJ (2005). "Detection of Burkholderia pseudomallei in soil within the Lao People's Democratic Republic". Journal of Clinical Microbiology. 43 (2): 923–924. doi:10.1128/JCM.43.2.923-924.2005. PMC 548109 . PMID 15695707.
71.Rattanavong S, Wuthiekanun V, Langla S, Amornchai P, Sirisouk J, Phetsouvanh R, Moore CE, Peacock SJ, Buisson Y, Newton PN (2010). "Randomized Soil Survey of the Distribution of Burkholderia pseudomallei in Rice Fields in Laos". Applied and Environmental Microbiology. 77 (2): 532–536. doi:10.1128/AEM.01822-10. PMC 3020526 . PMID 21075883.
72.Vongphayloth K, Rattanavong S, Moore CE, Phetsouvanh R, Wuthiekanun V, Sengdouangphachanh A, Phouminh P, Newton PN, Buisson Y (2012). "Burkholderia pseudomallei detection in surface water in southern Laos using Moore's swabs". American Journal of Tropical Medicine and Hygiene. 86 (5): 872–877. doi:10.4269/ajtmh.2012.11-0739. PMC 3335696 . PMID 22556090.
73.Lo TJ, Ang LW, James L, Goh KT (2009). "Melioidosis in a Tropical City State, Singapore". Emerging Infectious Diseases. 15 (10): 1645–1647. doi:10.3201/eid1510.090246. PMC 2866399 . PMID 19861063.
74.Kadir KA, Satyavani M, Pande K (2014). "Melioidosis: Antibiogram of cases in Brunei Darussalam" (PDF). Brunei International Medical Journal. 10 (1): 19–24.
75.Yang S (2000). "Melioidosis research in China". Acta Tropica. 77 (2): 157–165. doi:10.1016/S0001-706X(00)00139-X.
76.Ko, WC; Cheung, BM; Tang, HJ; Shih, HI; Lau, YJ; Wang, LR; Chuang, YC (2007). "Melioidosis Outbreak after Typhoon, Southern Taiwan". Emerging Infectious Diseases. 13 (6): 896–898. doi:10.3201/eid1306.060646. PMC 2792857 . PMID 17553230.
77.Chen YS, Lin HH, Mu JJ, Chiang CS, Chen CH, Buu LM, Lin YE, Chen YL (2010). "Distribution of Melioidosis Cases and Viable Burkholderia pseudomallei in Soil: Evidence for Emerging Melioidosis in Taiwan". Journal of Clinical Microbiology. 48 (4): 1432–1434. doi:10.1128/JCM.01720-09. PMC 2849618 . PMID 20147639.
78.Cheng AC, Currie BJ (2005). "Melioidosis: Epidemiology, Pathophysiology, and Management". Clinical Microbiology Reviews. 18 (2): 383–416. doi:10.1128/CMR.18.2.383-416.2005. PMC 1082802 . PMID 15831829.
79.http://www.abc.net.au/news/2017-01-09/melioidosis-risk-spreads-to-central-australia-heavy-rain/8169824
80.Chong VH (2010). "Changing spectrum of microbiology of liver abscess: Now Klebsiella, next Burkholderia pseudomallei". Journal of Emerging Medicine. 41 (6): 676–677. doi:10.1016/j.jemermed.2009.10.027. PMID 20079999.
81.Chugh TD (2008). "Emerging and re-emerging bacterial diseases in India". Journal of Bioscience. 33 (4): 549–555. doi:10.1007/s12038-008-0073-0. PMID 19208980.
82.Antony B, Pinto H, Dias M, Shetty AK, Scaria B, Kuruvilla T, Boloor R (2010). "Spectrum of melioidosis in the suburbs of Mangalore, S West Coast of India". Southeast Asian J Trop Med Public Health. 41 (1): 169–74.
83.Vidyalakshmi K, Chakrapani M, Shrikala B, Damodar S, Lipika S, Vishal S (2008). "Tuberculosis mimicked by melioidosis". International Journal of Tuberculosis and Lung Disease. 12 (10): 1209–1215.
84.Prakash A, Thavaselvam D, Kumar A et al. (2014). "Isolation, identification and characterization of Burkholderia pseudomallei from soil of coastal region of India". Springerplus. 3: 438. doi:10.1186/2193-1801-3-438. PMC4152474 . PMID25187882.
85.Inglis TJ, Rolim DB, De Queroz Sousa A (2006). "Melioidosis in the Americas". American Journal of Tropical Medicine and Hygiene. 75 (5): 947–954. PMID 17123994.
86.O'Sullivan BP, Torres B, Conidi G, et al. (2011). "Burkholderia pseudomallei infection in a child with cystic fibrosis: acquisition in the western hemisphere". Chest. 140 (1): 239–242. doi:10.1378/chest.10-3336. PMID 21729895.
87.Brilhante RS, Bandeira TJ, Cordeiro RA, et al. (2012). "Clinical-epidemiological features of 13 cases of melioidosis in Brazil". Journal of Clinical Microbiology. 50 (10): 3349–3352. doi:10.1128/JCM.01577-12. PMID 22814457.
88.Katangwe T, Purcell J, Bar-Zeev N, Denis B, Montgomery J, Alaerts M, Heyderman RS, Dance DA, Kennedy N, Feasey N, Moxon CA (2013). "Human melioidosis, Malawi, 2011". Emerging Infectious Diseases. 19 (6): 981–984. doi:10.3201/eid1906.120717. PMC 3713813 . PMID 23735189.
89.Morosini MI, Quereda C, Gil H, Anda P, Núñez-Murga M, Cantón R, López-Vélez R (2013). "Melioidosis in traveler from Africa to Spain". Emerging Infectious Diseases. 19 (10): 1656–1659. doi:10.3201/eid1910.121785. PMC 3810733 . PMID 24047798.
90.Struelens MJ, Mondol G, Bennish M, Dance DA (1998). "Melioidosis in Bangladesh: a case report". Transactions of the Royal Society of Tropical Medicine and Hygiene. 82 (5): 777–778. doi:10.1016/0035-9203(88)90234-9.
91.Hosen, Akram (30 Jul 2013). "Deadly bacteria in Gozipur soil". The Daily Star. Dhaka, Bangladesh. Archived from the original on 2013-07-21. Retrieved 30 Aug 2013.
92.Dance DA, Smith MD, Aucken HM, Pitt TL (1999). "Imported melioidosis in England and Wales". Lancet. 353 (9148): 208. doi:10.1016/S0140-6736(05)77217-2. PMID 9923882.
93."Burkholderia pseudomallei" (PDF). Mahout Microbiology Review. 7: 4. 2013. Retrieved 24 April 2016.
94.Limmathurotsakul, Direk; Golding, Nick; Dance, David A. B.; Messina, Jane P.; Pigott, David M.; Moyes, Catherine L.; Rolim, Dionne B.; Bertherat, Eric; Day, Nicholas P. J.; Peacock, Sharon J.; Hay, Simon I. (11 January 2016). "Predicted global distribution of Burkholderia pseudomallei and burden of melioidosis". Nature Microbiology. 1 (1): 15008. doi:10.1038/nmicrobiol.2015.8. PMC 4746747 . PMID 26877885.
95.Limmathurotsakul D, Wongratanacheewin S, Teerawattanasook N (2010). "Increasing Incidence of Human Melioidosis in Northeast Thailand". American Journal of Tropical Medicine and Hygiene. 82 (6): 1113–1117. doi:10.4269/ajtmh.2010.10-0038. PMC 2877420 . PMID 20519609.
96.Kanaphun P, Thirawattanasuk N, Suputtamongkol Y, et al. (1993). "Serology and carriage of Pseudomonas pseudomallei: a prospective study in 1000 hospitalized children in northeast Thailand". Journal of Infectious Diseases. 167 (1): 230–233. doi:10.1093/infdis/167.1.230. PMID 7678106.
97.Vuddhakul V, Tharavichitkul P, Na-Ngam N, et al. (March 1999). "Epidemiology of Burkholderia pseudomallei in Thailand". American Journal of Tropical Medicine and Hygiene. 60 (3): 4584–61. PMID 10466977.
98.Kanai K, Dejsirilert S (August 1988). "Pseudomonas pseudomallei and melioidosis, with special reference to the status in Thailand". Japanese Journal of Medical Science and Biology. 41 (4): 123–157. doi:10.7883/yoken1952.41.123. PMID 3075004.
99.Yang S, Tong S, Mo C, et al. (1998). "Prevalence of human melioidosis on Hainan Island in China". Microbiology and Immunology. 42 (9): 651–654. doi:10.1111/j.1348-0421.1998.tb02335.x. PMID 9802565.
100.Chen YS, Chen SC, Wu TR, Kao CM, Chen YL (October 2004). "Seroprevalence of anti-flagellin antibody against Burkholderia pseudomallei in Taiwan". Japanese Journal of Infectious Diseases. 57 (5): 224–225. PMID 15507783.
101.Parkes, Helen M.; Shilton, Catherine M.; Jerrett, Ian V.; Benedict, Suresh; Spratt, Brian G.; Godoy, Daniel; O'Brien, Carolyn R.; Krockenberger, Mark B.; et al. (2009). "Primary ocular melioidosis due to a single genotype of Burkholderia pseudomallei in two cats from Arnhem Land in the Northern Territory of Australia". Journal of Feline Medicine and Surgery. 11 (10): 856–863. doi:10.1016/j.jfms.2009.02.009. PMID 19428280.
102.Sprague LD, Neubauer H (2004). "Melioidosis in Animals: A review on epizootiology, diagnosis and clinical presentation". Journal of Veterinary Medicine. B, Infectious Diseases and Veterinary Public Health. 51 (7): 305–320. doi:10.1111/j.1439-0450.2004.00797.x. PMID15525357.
103.Mollaret HH (1988). ""L'affaire du Jardin des plantes" ou comment le mélioïdose fit son apparition en France". Médecine et Maladies Infectieuses. 18 (Suppl 4): 643–654. doi:10.1016/S0399-077X(88)80175-6.
104.Corkeron ML, Norton R, Nelson PN (2010). "Spatial analysis of melioidosis distribution in a suburban area". Epidemiology and Infection. 138 (9): 1346–1352. doi:10.1017/S0950268809991634. PMID 20092666.
105.Chantratita N, Wuthiekanun V, Limmathurotsakul D, et al. (2008). Currie B, ed. "Genetic Diversity and Microevolution of Burkholderia pseudomallei in the Environment". PLoS Neglected Tropical Diseases. 2 (2): e182. doi:10.1371/journal.pntd.0000182. PMC 2254201 . PMID 18299706.
106.Lin HH; Chen YS; Li YC; e al. (2011). "Burkholderia multivorans acts as an antagonist against the growth of Burkholderia pseudomallei in soil". Microbiology and Immunology. 55 (9): 616–624. doi:10.1111/j.1348-0421.2011.00365.x. PMID 21752084.
107.Inglis TJ, Garrow SC, Henderson M, Clair A, Sampson J, O'Reilly L, Cameron B (2000). "Burkholderia pseudomallei traced to water treatment plant in Australia". Emerging Infectious Diseases. 6 (1): 56–559. doi:10.3201/eid0601.000110. PMC 2627980 . PMID 10653571.
108.Apisarnthanarak A, Khawcharoenporn T, Mundy LM (2012). "Flood-associated melioidosis in a non-endemic region of Thailand". International Journal of Infectious Diseases. 16 (5): e409–410. doi:10.1016/j.ijid.2012.01.013. PMID 22421023.
109.Chierakul W, Winothai W, Wattanawaitunechai C, et al. (2005). "Melioidosis in 6 tsunami survivors in southern Thailand". Clinical Infectious Diseases. 41 (7): 982–990. doi:10.1086/432942. PMID 16142663.
110.Ko WC, Cheung BM, Tang HJ, Shih HI, Lau YJ, Wang LR, Chuang YC (2007). "Melioidosis outbreak after typhoon, southern Taiwan". Emerging Infectious Diseases. 13 (6): 896–898. doi:10.3201/eid1306.060646. PMC 2792857 . PMID 17553230.
111.Inglis TJ, O'Reilly L, Merritt AJ, Levy A, Heath CH (2011). "The aftermath of the Western Australian melioidosis outbreak". American Journal of Tropical Medicine and Hygiene. 84 (6): 851–857. doi:10.4269/ajtmh.2011.10-0480. PMID 21633018.
112.Baker A, Pearson T, Price EP, et al. (2011). "Molecular Phylogeny of Burkholderia pseudomallei from a Remote Region of Papua New Guinea". PLoS onE. 6 (3): e18343. doi:10.1371/journal.pone.0018343. PMC 3069084 . PMID 21483841.
113.Suputtamongkol Y, Chaowagul W, Chetchotisakd P, et al. (1999). "Risk factors for melioiosis and bacteremic melioidosis". Clinical Infectious Diseases. 29 (2): 408–413. doi:10.1086/520223. PMID10476750.
114.Phe T, Vlieghe E, Reid T, et al. (2013). "Does HIV status affect the aetiology, bacterial resistance patterns and recommended empiric antibiotic treatment in adult patients with bloodstream infection in Cambodia?". Tropical Medicine and International Health. 18 (4): 485–494. doi:10.1111/tmi.12060. PMID 23294446.
115.Kanai K, Kurata T, Akksilp S, et al. (1992). "A preliminary survey for human immunodeficient virus (HIV) infections in tuberculosis and melioidosis patients in Ubon Ratchathani, Thailand". Japanese Journal of Medical Science and Biology. 45 (5–6): 247–253. doi:10.7883/yoken1952.45.247. PMID 1306871.
116.Chierakul W, Wuthiekanun V, Chaowagul W, et al. (2005). "Short report: disease severity and outcome of melioidosis in HIV coinfected individuals". American Journal of Tropical Medicine and Hygiene. 73 (6): 1165–1166. PMID 16354832.
117.Suputtamongkol Y, Hall AJ, Dance DA, et al. (1994). "The epidemiology of melioidosis in Ubon Ratchatani, Northeast Thailand". International Journal of Epidemiology. 23 (5): 1082–1089. doi:10.1093/ije/23.5.1082. PMID 7860160.
118.Currie BJ, Jacups SP (December 2003). "Intensity of Rainfall and Severity of Melioidosis, Australia". Emerging Infectious Diseases. 9 (12): 1538–1542. doi:10.3201/eid0912.020750. PMC 3034332 . PMID 14720392.
119.Liu Y, Loh JP, Aw LT, Yap EP, Lee MA, Ooi EE (2006). "Rapid molecular typing of Burkholderia pseudomallei, isolated in an outbreak of melioidosis in Singapore in 2004, based on variable-number tandem repeats". Transactions of the Royal Society of Tropical Medicine and Hygiene. 100 (7): 687–692. doi:10.1016/j.trstmh.2005.08.017. PMID 16343569.
120.Sam IC, Puthucheary SD (2007). "Melioidosis and rainfall in Kuala Lumpur, Malaysia". Journal of Infection. 54 (5): 519–520. doi:10.1016/j.jinf.2006.07.007. PMID 16965821.
121.Baker, Anthony L.; Ezzahir, Jessica; Gardiner, Christopher; Shipton, Warren; Warner, Jeffrey M.; Wooten, R. Mark (23 September 2015). "Environmental Attributes Influencing the Distribution of Burkholderia pseudomallei in Northern Australia". PLOS onE. 10 (9): e0138953. doi:10.1371/journal.pone.0138953. PMC 4580599 . PMID 26398904.
122.Whitmore, A; Krishnaswami, CS (1912). "An account of the discovery of a hitherto undescribed infectious disease among the population of Rangoon". Indian Medical Gazette. 47: 262–267.
123.Strong, Richard P (1944). Stitt's Diagnosis, Prevention and Treatment of Tropical Diseases (7th ed.). Philadelphia: The Blakiston Company. p. 732.
124.Vora SK (February 2002). "Sherlock Holmes and a biological weapon". Journal of the Royal Society of Medicine. 95 (2): 101–103. doi:10.1258/jrsm.95.2.101. PMC 1279324 . PMID 11823558.
125.Whitmore A, Krishnaswami CS (1912). "An account of the discovery of a hitherto undescribed infective disease occurring among the population of Rangoon". Indian Medical Gazette. 92: 262–267.
126.Barker A (19 June 2005). "Rise in melioidosis rates in NT". Australian Broadcasting Corporation. Retrieved 2007-06-24.
127.Orellana C (November 2004). "Melioidosis strikes Singapore". Lancet Infect Dis. 4 (11): 655. doi:10.1016/S1473-3099(04)01190-9. PMID 15534940.
128.C S Krishnaswami. "Morphia injectors' septicaemia". Indian Medical Gazette. 52 (1917): 296–299.